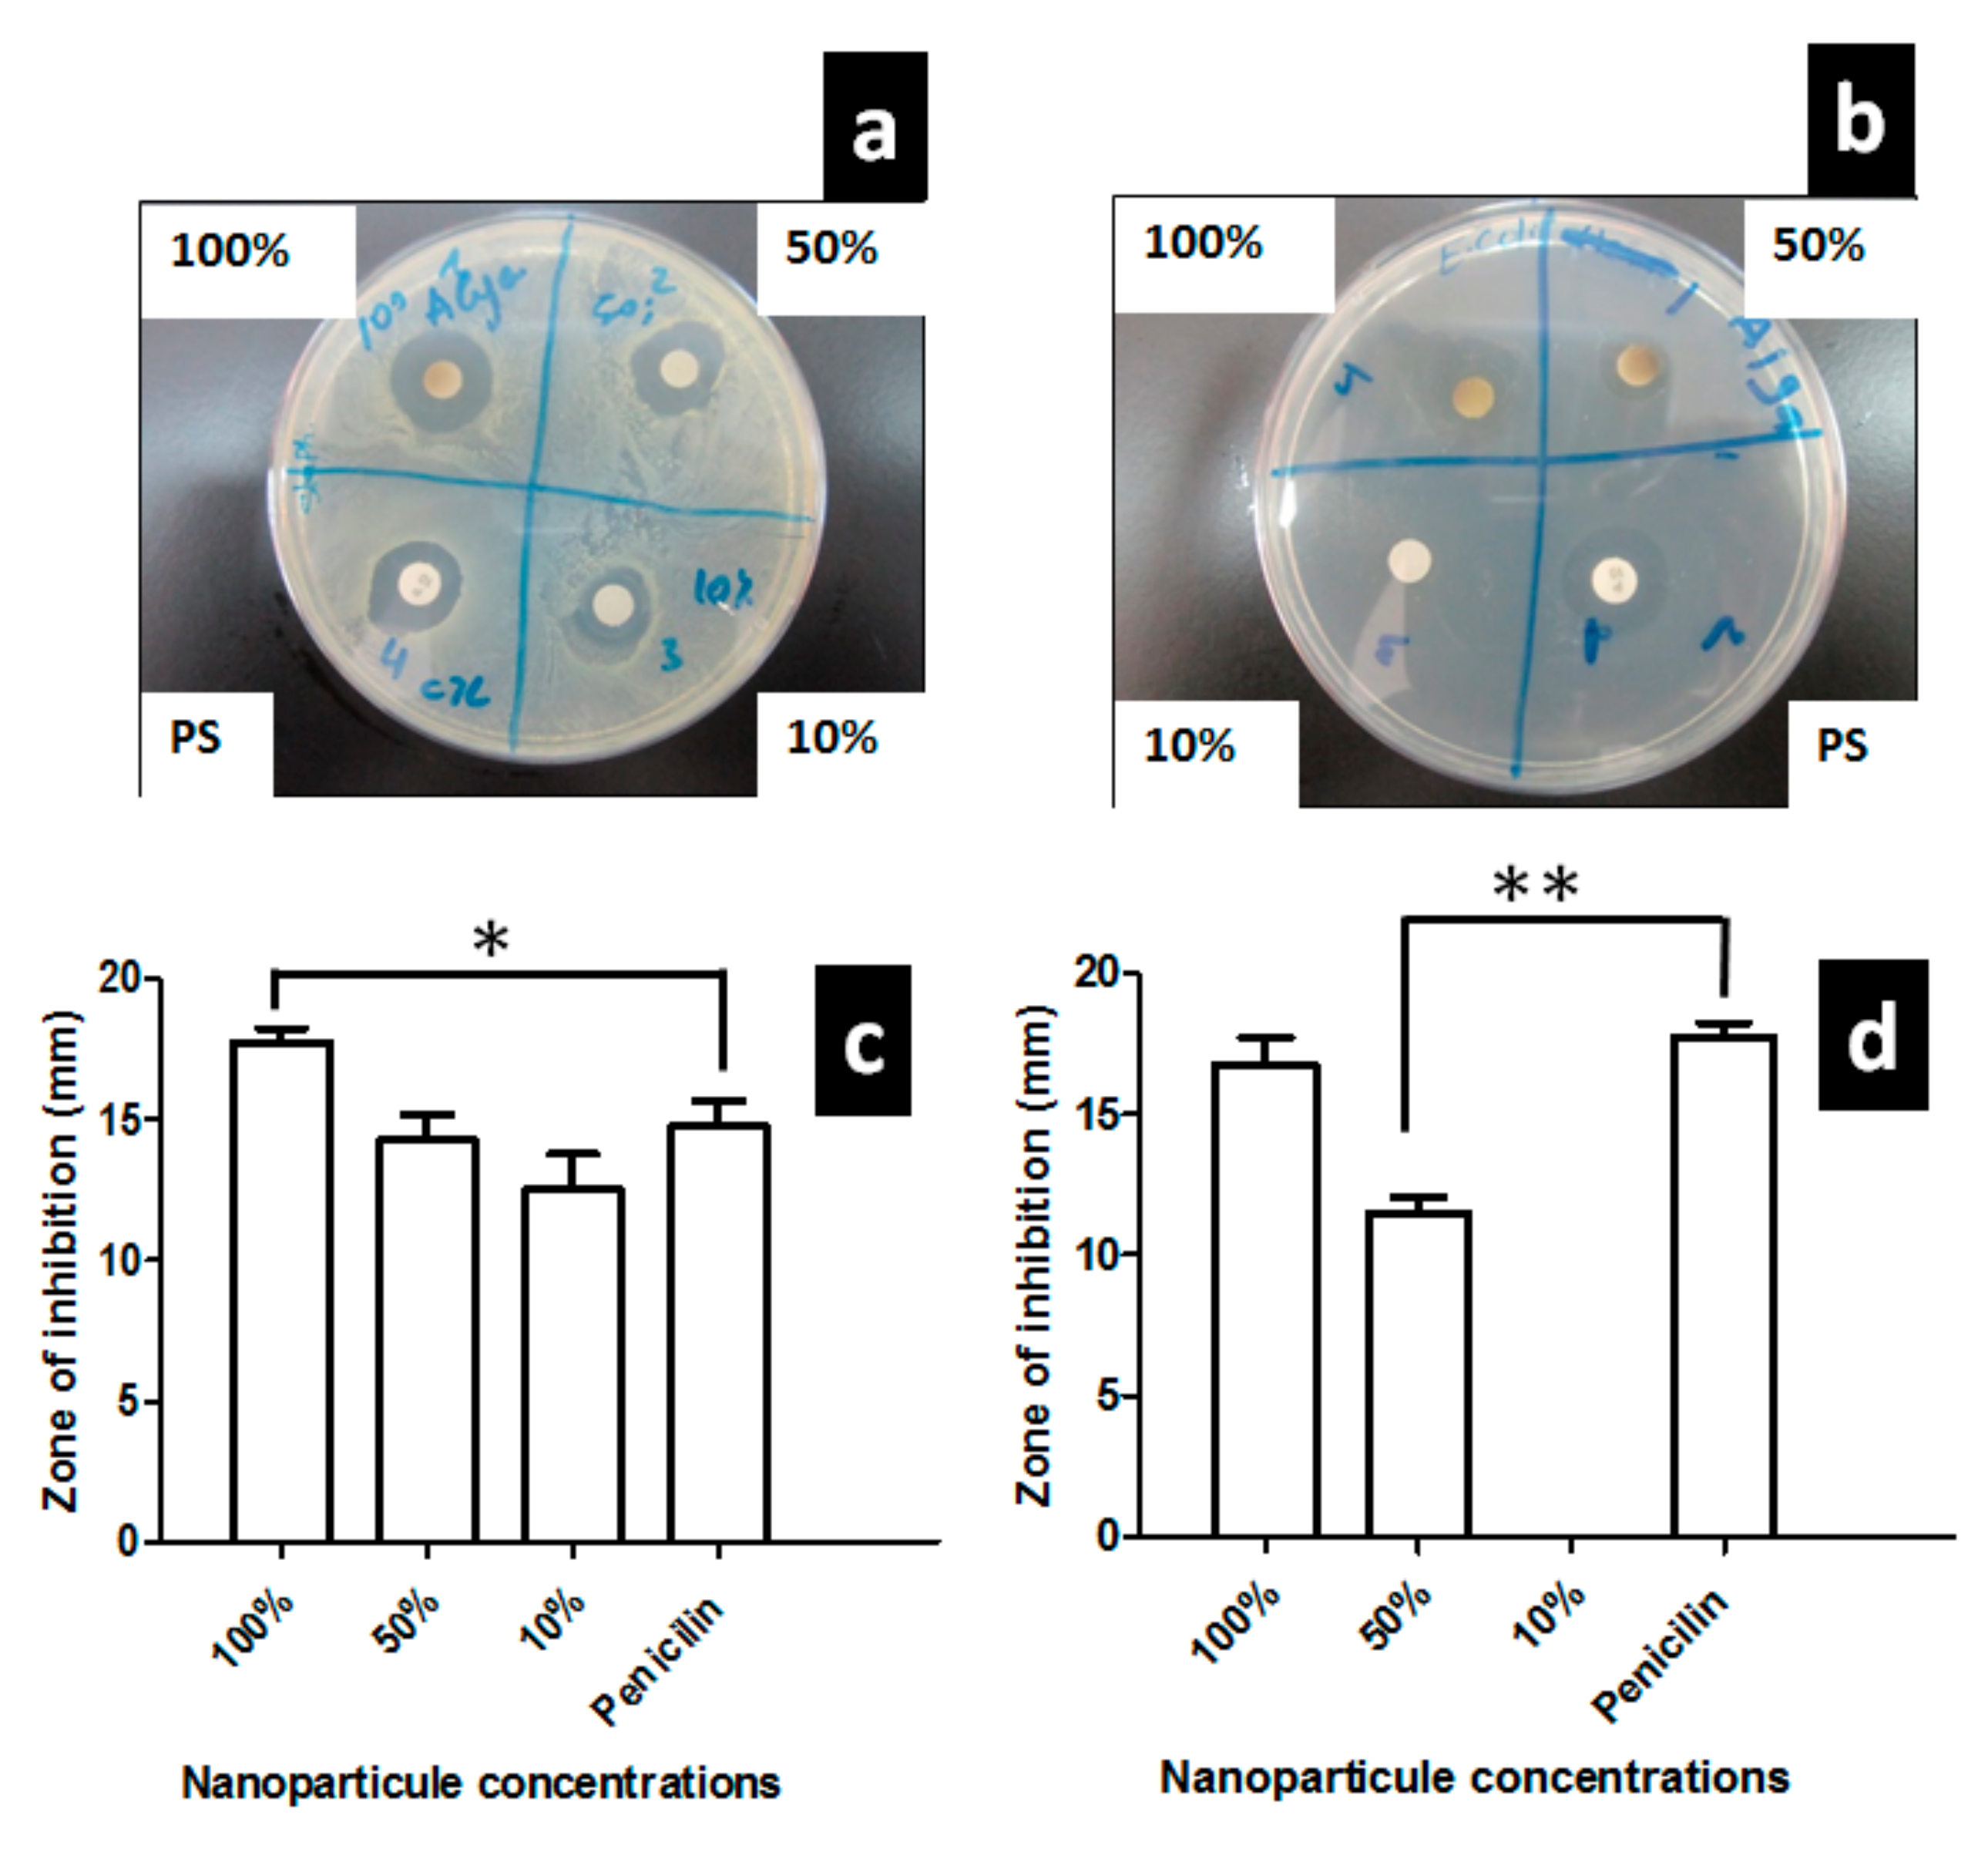
Nanomaterials 10 01861 g006 Nanomaterials 10 01861 g006

Green Synthesis, Characterization, Antimicrobial, Anti-Cancer, and Optimization of Colorimetric Sensing of Hydrogen Peroxide of Algae Extract Capped Silver Nanoparticles
Abstract
1. Introduction
2. Experimental Part
2.1. Algae Collection and Plant Extract Preparation
2.2. Materials and Reagents
2.3. Instrumentation
2.4. Synthesis of Algae Extract Stabilized Silver Nanoparticles
2.5. Effect of AgNO3 Concentration and Plant Extract Ratio (Plant Extract/AgNO3) on the Formation of Nanoparticles and the Effect of Algae-AgNPs Volume on the Detection of H2O2
2.6. Effect of Time on the Preparation of Algae-AgNPs and on the Detection of H2O2 at 25 °C
2.7. Effect of pH on the Preparation of Algae-AgNPs and Detection of H2O2 at 25 °C
2.8. Effect of the Temperature on the Preparation of Algae-AgNPs and H2O2 Detection
2.9. Calibration Curves and Unknown Analysis
2.10. Disk Diffusion Test
2.11. Anti-Cancer Cell Proliferation
2.12. Statistical Analysis
3. Results and Discussion
4. Conclusions
Supplementary Materials
Author Contributions
Funding
Acknowledgments
Conflicts of Interest
References
- DiBianco, J.M.; Lange, J.; Heidenberg, D.; Mufarrij, P. Oxygen Venous Embolism After Hydrogen Peroxide Use During Percutaneous Nephrolithotomy. J. Endourol. Case Rep. 2019, 5, 25–27. [Google Scholar] [CrossRef] [PubMed]
- Matin, A.R.; Yousefzadeh, S.; Ahmadi, E.; Mahvi, A.; Alimohammadi, M.; Aslani, H.; Nabizadeh, R. A comparative study of the disinfection efficacy of H2O2/ferrate and UV/H2O2/ferrate processes on inactivation of Bacillus subtilis spores by response surface methodology for modeling and optimization. Food Chem. Toxicol. 2018, 116, 129–137. [Google Scholar] [CrossRef] [PubMed]
- Flores, M.J.; Brandi, R.J.; Cassano, A.E.; Labas, M.D. Chemical disinfection with H2O2—The proposal of a reaction kinetic model. Chem. Eng. J. 2012, 198–199, 388–396. [Google Scholar] [CrossRef]
- Nichols, J.J.; Chalmers, R.L.; Dumbleton, K.; Jones, L.; Lievens, C.W.; Merchea, M.M.; Szczotka-Flynn, L. The Case for Using Hydrogen Peroxide Contact Lens Care Solutions: A Review. Eye Contact Lens 2019, 45, 69–82. [Google Scholar] [CrossRef] [PubMed]
- Medical Management Guidelines for Hydrogen Peroxide. Available online: https://www.atsdr.cdc.gov/MMG/MMG.asp?id=304&tid=55 (accessed on 26 August 2020).
- Hertzberger, R.; Arents, J.; Dekker, H.L.; Pridmore, R.D.; Gysler, C.; Kleerebezem, M.; de Mattos, M. Joost Teixeira H2O2 production in species of the Lactobacillus acidophilus group: A central role for a novel NADH-dependent flavin reductase. Appl. Environ. Microbiol. 2014, 80, 2229–2239. [Google Scholar] [CrossRef]
- Hammami, R.; Ismail, F.; Corsetti, A. Application of protective cultures and bacteriocins for food biopreservation. Front. Microbiol. 2019, 10, 1561. [Google Scholar] [CrossRef]
- Karimi, A.; Husain, S.W.; Hosseini, M.; Azar, P.A.; Ganjali, M.R. Rapid and sensitive detection of hydrogen peroxide in milk by Enzyme-free electrochemiluminescence sensor based on a polypyrrole-cerium oxide nanocomposite. Sens. Actuators B Chem. 2018, 271, 90–96. [Google Scholar] [CrossRef]
- Al-Shehri, S.S.; Knox, C.L.; Liley, H.G.; Cowley, D.M.; Wright, J.R.; Henman, M.G.; Hewavitharana, A.K.; Charles, B.G.; Shaw, P.N.; Sweeney, E.L. Breastmilk-saliva interactions boost innate immunity by regulating the oral microbiome in early infancy. PLoS ONE 2015, 10, e0135047. [Google Scholar] [CrossRef]
- Matos, C.; Ribeiro, M.; Guerra, A. Breastfeeding: Antioxidative properties of breast milk. J. Appl. Biomed. 2015, 13, 169–180. [Google Scholar] [CrossRef]
- Forman, H.J.; Bernardo, A.; Davies, K.J. What is the concentration of hydrogen peroxide in blood and plasma? Arch. Biochem. Biophys. 2016, 603, 48–53. [Google Scholar] [CrossRef]
- Rio, M.; Velez-Pardo, C. The hydrogen peroxide and its importance in Alzheimer’s and Parkinson’s disease. Curr. Med. Chem. Cent. Nerv. Syst. Agents 2004, 4, 279–285. [Google Scholar]
- Anonymous. Questionable methods of cancer management: Hydrogen peroxide and other‘hyperoxygenation’ therapies. CA Cancer J. Clin. 1993, 43, 47–56. [Google Scholar] [CrossRef] [PubMed]
- FDA Warns Consumers Against Drinking High-Strength Hydrogen Peroxide for Medicinal Use. Ingestion Can Lead to Serious Health Risks and Death. Available online: https://www.sciencedaily.com/releases/2006/07/060730134156.htm (accessed on 24 September 2019).
- Elgamouz, A.; Bajou, K.; Hafez, B.; Nassab, C.; Behi, A.; Haija, M.A.; Patole, S.P. Optical Sensing of Hydrogen Peroxide Using Starch Capped Silver Nanoparticles, Synthesis, Optimization and Detection in Urine. Sens. Actuators Rep. 2020, 2, 100014. [Google Scholar] [CrossRef]
- Ju-Nam, Y.; Lead, J.R. Manufactured nanoparticles: An overview of their chemistry, interactions and potential environmental implications. Sci. Total Environ. 2008, 400, 396–414. [Google Scholar] [CrossRef]
- Brown, P.K.; Qureshi, A.T.; Moll, A.N.; Hayes, D.J.; Monroe, W.T. Silver nanoscale antisense drug delivery system for photoactivated gene silencing. ACS Nano 2013, 7, 2948–2959. [Google Scholar] [CrossRef]
- Owoseni-Fagbenro, K.A.; Saifullah, S.; Imran, M.; Perveen, S.; Rao, K.; Fasina, T.M.; Olasupo, I.A.; Adams, L.A.; Ali, I.; Shah, M.R. Egg proteins stabilized green silver nanoparticles as delivery system for hesperidin enhanced bactericidal potential against resistant S. aureus. J. Drug Deliv. Sci. Technol. 2019, 50, 347–354. [Google Scholar] [CrossRef]
- Shankar, S.S.; Rai, A.; Ahmad, A.; Sastry, M. Rapid synthesis of Au, Ag, and bimetallic Au core–Ag shell nanoparticles using Neem (Azadirachta indica) leaf broth. J. Colloid Interface Sci. 2004, 275, 496–502. [Google Scholar] [CrossRef]
- Sharma, V.K.; Yngard, R.A.; Lin, Y. Silver nanoparticles: Green synthesis and their antimicrobial activities. Adv. Colloid Interface Sci. 2009, 145, 83–96. [Google Scholar] [CrossRef]
- Ahmed, S.; Ahmad, M.; Swami, B.L.; Ikram, S. A review on plants extract mediated synthesis of silver nanoparticles for antimicrobial applications: A green expertise. J. Adv. Res. 2016, 7, 17–28. [Google Scholar] [CrossRef]
- Katas, H.; Moden, N.Z.; Lim, C.S.; Celesistinus, T.; Chan, J.Y.; Ganasan, P.; Suleman Ismail Abdalla, S. Biosynthesis and potential applications of silver and gold nanoparticles and their chitosan-based nanocomposites in nanomedicine. J. Nanotechnol. 2018, 2018. [Google Scholar] [CrossRef]
- Li, B.; Li, X.; Dong, Y.; Wang, B.; Li, D.; Shi, Y.; Wu, Y. Colorimetric sensor array based on gold nanoparticles with diverse surface charges for microorganisms identification. Anal. Chem. 2017, 89, 10639–10643. [Google Scholar] [CrossRef] [PubMed]
- Yew, C.T.; Azari, P.; Choi, J.R.; Li, F.; Pingguan-Murphy, B. Electrospin-coating of nitrocellulose membrane enhances sensitivity in nucleic acid-based lateral flow assay. Anal. Chim. Acta. 2018, 1009, 81–88. [Google Scholar] [CrossRef] [PubMed]
- Mohammadpour, R.; Dobrovolskaia, M.A.; Cheney, D.L.; Greish, K.F.; Ghandehari, H. Subchronic and chronic toxicity evaluation of inorganic nanoparticles for delivery applications. Adv. Drug Deliv. Rev. 2019, 144, 112–132. [Google Scholar] [CrossRef] [PubMed]
- Bagherzade, G.; Tavakoli, M.M.; Namaei, M.H. Green synthesis of silver nanoparticles using aqueous extract of saffron (Crocus sativus L.) wastages and its antibacterial activity against six bacteria. Asian Pac. J. Trop. Biomed. 2017, 7, 227–233. [Google Scholar] [CrossRef]
- Hamelian, M.; Zangeneh, M.M.; Amisama, A.; Varmira, K.; Veisi, H. Green synthesis of silver nanoparticles using Thymus kotschyanus extract and evaluation of their antioxidant, antibacterial and cytotoxic effects. Appl. Organomet. Chem. 2018, 32, e4458. [Google Scholar] [CrossRef]
- Hasan, K.; Shehadi, I.A.; Al-Bab, N.D.; Elgamouz, A. Magnetic Chitosan-Supported Silver Nanoparticles: A Heterogeneous Catalyst for the Reduction of 4-Nitrophenol. Catalysts 2019, 9, 839. [Google Scholar] [CrossRef]
- Elgamouz, A.; Alsaidi, R.; Alsaidi, A.; Zahri, M.; Almehdi, A.; Bajou, K. Dataset in the characterization of black spot Ehrenberg snapper and its proteins’ denaturation inhibition by natural antioxidants. Data Brief 2020, 28, 104927. [Google Scholar] [CrossRef]
- Elgamouz, A.; Alsaidi, R.; Alsaidi, A.; Zahri, M.; Almehdi, A.; Bajou, K. The Effects of Storage on Quality and Nutritional Values of Ehrenberg’s Snapper Muscles (Lutjanus Ehrenbergi): Evaluation of Natural Antioxidants Effect on the Denaturation of Proteins. Biomolecules 2019, 9, 442. [Google Scholar] [CrossRef]
- Jatoi, A.W.; Kim, I.S.; Ni, Q.Q. A comparative study on synthesis of AgNPs on cellulose nanofibers by thermal treatment and DMF for antibacterial activities. Mater. Sci. Eng. C 2019, 98, 1179–1195. [Google Scholar] [CrossRef]
- Manukumar, H.M.; Umesha, S.; Kumar, H.N.N. Promising biocidal activity of thymol loaded chitosan silver nanoparticles (T-C@AgNPs) as anti-infective agents against perilous pathogens. Int. J. Biol. Macromol. 2017, 102, 1257–1265. [Google Scholar] [CrossRef]
- Nguyen, T.; Dang, C.; Mai, D. Biosynthesized AgNP capped on novel nanocomposite 2-hydroxypropyl-β-cyclodextrin/alginate as a catalyst for degradation of pollutants. Carbohydr. Polym. 2018, 197, 29–37. [Google Scholar] [CrossRef] [PubMed]
- Jatoi, A.W.; Kim, I.S.; Ni, Q. Cellulose acetate nanofibers embedded with AgNPs anchored TiO2 nanoparticles for long term excellent antibacterial applications. Carbohydr. Polym. 2019, 207, 640–649. [Google Scholar] [CrossRef] [PubMed]
- Tavaf, Z.; Tabatabaei, M.; Khalafi-Nezhad, A.; Panahi, F. Evaluation of antibacterial, antibofilm and antioxidant activities of synthesized silver nanoparticles (AgNPs) and casein peptide fragments against Streptococcus mutans. Eur. J. Integr. Med. 2017, 12, 163–171. [Google Scholar] [CrossRef]
- Sprynskyy, M.; Sokol, H.; Rafińska, K.; Brzozowska, W.; Railean-Plugaru, V.; Pomastowski, P.; Buszewski, B. Preparation of AgNPs/saponite nanocomposites without reduction agents and study of its antibacterial activity. Colloids Surf. B Biointerfaces 2019, 180, 457–465. [Google Scholar] [CrossRef] [PubMed]
- Choudhary, M.K.; Garg, S.; Kaur, A.; Kataria, J.; Sharma, S. Green biomimetic silver nanoparticles as invigorated colorimetric probe for Hg2+ ions: A cleaner approach towards recognition of heavy metal ions in aqueous media. Mater. Chem. Phys. 2020, 240, 122164. [Google Scholar] [CrossRef]
- Torrent, L.; Iglesias, M.; Marguí, E.; Hidalgo, M.; Verdaguer, D.; Llorens, L.; Kodre, A.; Kavčič, A.; Vogel-Mikuš, K. Uptake, translocation and ligand of silver in Lactuca sativa exposed to silver nanoparticles of different size, coatings and concentration. J. Hazard. Mater. 2020, 384, 121201. [Google Scholar] [CrossRef]
- Deepika, S.; Selvaraj, C.I.; Roopan, S.M. Screening bioactivities of Caesalpinia pulcherrima L. swartz and cytotoxicity of extract synthesized silver nanoparticles on HCT116 cell line. Mater. Sci. Eng. C 2020, 106, 110279. [Google Scholar] [CrossRef]
- Fahimirad, S.; Ajalloueian, F.; Ghorbanpour, M. Synthesis and therapeutic potential of silver nanomaterials derived from plant extracts. Ecotoxicol. Environ. Saf. 2019, 168, 260–278. [Google Scholar] [CrossRef]
- Kim, J.H.; Lee, J.; Kim, K.H.; Kang, N.J. Beneficial effects of marine algae-derived carbohydrates for skin health. Mar. Drugs 2018, 16, 459. [Google Scholar] [CrossRef]
- Snelgrove, P.V. An ocean of discovery: Biodiversity beyond the census of marine life. Planta Med. 2016, 82, 790–799. [Google Scholar] [CrossRef]
- Teodoro, K.B.R.; Migliorini, F.L.; Christinelli, W.A.; Correa, D.S. Detection of hydrogen peroxide (H2O2) using a colorimetric sensor based on cellulose nanowhiskers and silver nanoparticles. Carbohydr. Polym. 2019, 212, 235–241. [Google Scholar] [CrossRef] [PubMed]
- Michalak, I.; Chojnacka, K. Algae as production systems of bioactive compounds. Eng. Life Sci. 2015, 15, 160–176. [Google Scholar] [CrossRef]
- Fu, W.; Nelson, D.R.; Yi, Z.; Xu, M.; Khraiwesh, B.; Jijakli, K.; Chaiboonchoe, A.; Alzahmi, A.; Al-Khairy, D.; Brynjolfsson, S. Bioactive compounds from microalgae: Current development and prospects. Stud. Nat. Prod. Chem. 2017, 54, 199–225. [Google Scholar]
- Hebeish, A.; Shaheen, T.I.; El-Naggar, M.E. Solid state synthesis of starch-capped silver nanoparticles. Int. J. Biol. Macromol. 2016, 87, 70–76. [Google Scholar] [CrossRef] [PubMed]
- Liu, H.; Zhang, H.; Wang, J.; Wei, J. Effect of temperature on the size of biosynthesized silver nanoparticle: Deep insight into microscopic kinetics analysis. Arab. J. Chem. 2020, 13, 1011–1019. [Google Scholar] [CrossRef]
- Zabell, A.P.R.; Lytle, F.E.; Julian, R.K. A proposal to improve calibration and outlier detection in high-throughput mass spectrometry. Clin. Mass Spectrom. 2016, 2, 25–33. [Google Scholar] [CrossRef]
- Wang, Y.; Xu, L.; Xie, W. Rapid and sensitive colorimetric sensor for H2O2 and Hg2+ detection based on homogeneous iodide with high peroxidase-mimicking activity. Microchem. J. 2019, 147, 75–82. [Google Scholar] [CrossRef]
- Nguyen, N.D.; Nguyen, T.V.; Chu, A.D.; Tran, H.V.; Tran, L.T.; Huynh, C.D. A label-free colorimetric sensor based on silver nanoparticles directed to hydrogen peroxide and glucose. Arab. J. Chem. 2018, 11, 1134–1143. [Google Scholar] [CrossRef]
- Farrokhnia, M.; Karimi, S.; Momeni, S.; Khalililaghab, S. Colorimetric sensor assay for detection of hydrogen peroxide using green synthesis of silver chloride nanoparticles: Experimental and theoretical evidence. Sens. Actuators B Chem. 2017, 246, 979–987. [Google Scholar] [CrossRef]
- Guo, J.; Wang, Y.; Zhao, M. 3D flower-like ferrous(II) phosphate nanostructures as peroxidase mimetics for sensitive colorimetric detection of hydrogen peroxide and glucose at nanomolar level. Talanta 2018, 182, 230–240. [Google Scholar] [CrossRef]
- Chen, J.; Shu, Y.; Li, H.; Xu, Q.; Hu, X. Nickel metal-organic framework 2D nanosheets with enhanced peroxidase nanozyme activity for colorimetric detection of H2O2. Talanta 2018, 189, 254–261. [Google Scholar] [CrossRef]
- Bian, T.; Liu, H.; Sun, B.; Xiao, B.; Jiang, Y.; Jin, C.; Yuan, A.; Zhang, H.; Yang, D. Ion-templated fabrication of Pt-Cu alloy octahedra with controlled compositions for electrochemical detection of H2O2. J. Alloy. Compd. 2019, 788, 1334–1340. [Google Scholar] [CrossRef]
- Fatima, R.; Priya, M.; Indurthi, L.; Radhakrishnan, V.; Sudhakaran, R. Biosynthesis of silver nanoparticles using red algae Portieria hornemannii and its antibacterial activity against fish pathogens. Microb. Pathog. 2020, 138, 103780. [Google Scholar] [CrossRef]
- Yun’an Qing, L.C.; Li, R.; Liu, G.; Zhang, Y.; Tang, X.; Wang, J.; Liu, H.; Qin, Y. Potential antibacterial mechanism of silver nanoparticles and the optimization of orthopedic implants by advanced modification technologies. Int. J. Nanomed. 2018, 13, 3311. [Google Scholar] [CrossRef]
- Sonohara, R.; Muramatsu, N.; Ohshima, H.; Kondo, T. Difference in surface properties between Escherichia coli and Staphylococcus aureus as revealed by electrophoretic mobility measurements. Biophys. Chem. 1995, 55, 273–277. [Google Scholar] [CrossRef]
- Zhong, X.; Song, Y.; Yang, P.; Wang, Y.; Jiang, S.; Zhang, X.; Li, C. Titanium surface priming with phase-transited lysozyme to establish a silver nanoparticle-loaded chitosan/hyaluronic acid antibacterial multilayer via layer-by-layer self-assembly. PLoS ONE 2016, 11, e0146957. [Google Scholar] [CrossRef]
- Jin, J.; Wu, X.; Xu, J.; Wang, B.; Jiang, F.; Liu, Y. Ultrasmall silver nanoclusters: Highly efficient antibacterial activity and their mechanisms. Biomater. Sci. 2017, 5, 247–257. [Google Scholar] [CrossRef]
- Kim, T.; Braun, G.B.; She, Z.; Hussain, S.; Ruoslahti, E.; Sailor, M.J. Composite Porous silicon–silver nanoparticles as theranostic antibacterial agents. ACS Appl. Mater. Interfaces 2016, 8, 30449–30457. [Google Scholar] [CrossRef]
- Schreurs, W.J.; Rosenberg, H. Effect of silver ions on transport and retention of phosphate by Escherichia coli. J. Bacteriol. 1982, 152, 7–13. [Google Scholar]
- Holt, K.B.; Bard, A.J. Interaction of silver (I) ions with the respiratory chain of Escherichia coli: An electrochemical and scanning electrochemical microscopy study of the antimicrobial mechanism of micromolar Ag. Biochemistry 2005, 44, 13214–13223. [Google Scholar] [CrossRef]
- Monteiro, D.R.; Gorup, L.F.; Takamiya, A.S.; de Camargo, E.R.; Filho, A.C.R.; Barbosa, D.B. Silver distribution and release from an antimicrobial denture base resin containing silver colloidal nanoparticles. J. Prosthodont. Implant Esthet. Reconstr. Dent. 2012, 21, 7–15. [Google Scholar] [CrossRef] [PubMed]
- Gurunathan, S.; Kim, E.; Han, J.; Park, J.; Kim, J. Green chemistry approach for synthesis of effective anticancer palladium nanoparticles. Molecules 2015, 20, 22476–22498. [Google Scholar] [CrossRef] [PubMed]
- Carlson, C.; Hussain, S.M.; Schrand, A.M.; Braydich-Stolle, L.K.; Hess, K.L.; Jones, R.L.; Schlager, J.J. Unique cellular interaction of silver nanoparticles: Size-dependent generation of reactive oxygen species. J. Phys. Chem. B 2008, 112, 13608–13619. [Google Scholar] [CrossRef] [PubMed]
- Yuan, Y.; Zhang, S.; Hwang, J.; Kong, I. Silver Nanoparticles Potentiates Cytotoxicity and Apoptotic Potential of Camptothecin in Human Cervical Cancer Cells. Oxidative Med. Cell. Longev. 2018, 2018. [Google Scholar] [CrossRef]

| Method | Limit of Detection (LOD) | Linear Range | Reference |
|---|---|---|---|
| SAgNPs | 3.70 µM | 0.45–121 µM | [15] |
| 10.5 nM | 4.70–32.0 nM | ||
| TMB + H2O2 + I− reaction | 1.1 μM | 1.7–166.7 μM | [49] |
| AgNPs/GQDs | 30 μM | 0.5–8 mM | [50] |
| Brown Algae AgNPs | 8.6 nM | 1–120 μM | [51] |
| (Fe3(PO4)2·8H2O NFs) | 5.0 nM | 1 × 10−5–2.5 mM | [52] |
| Ni-MOF nanosheet | 8.0 nM | 0.04–160 μM | [53] |
| Cellulose AgNPs | 112 µM | 60–600 µM | [43] |
| Pt-Cu nanoparticles | 0.17 μM | 0.50 μM–22.3 mM | [54] |
| Colorimetric sensor Algae-AgNPs | Abs 1.34 ± 0.02 nM | 4.70–32.0 nM | This work |
| ΔAbs 1.78 ± 0.02 nM | 4.70–32.0 nM |
© 2020 by the authors. Licensee MDPI, Basel, Switzerland. This article is an open access article distributed under the terms and conditions of the Creative Commons Attribution (CC BY) license (http://creativecommons.org/licenses/by/4.0/).
Share and Cite
Elgamouz, A.; Idriss, H.; Nassab, C.; Bihi, A.; Bajou, K.; Hasan, K.; Abu Haija, M.; Patole, S.P. Green Synthesis, Characterization, Antimicrobial, Anti-Cancer, and Optimization of Colorimetric Sensing of Hydrogen Peroxide of Algae Extract Capped Silver Nanoparticles. Nanomaterials 2020, 10, 1861. https://doi.org/10.3390/nano10091861
Elgamouz A, Idriss H, Nassab C, Bihi A, Bajou K, Hasan K, Abu Haija M, Patole SP. Green Synthesis, Characterization, Antimicrobial, Anti-Cancer, and Optimization of Colorimetric Sensing of Hydrogen Peroxide of Algae Extract Capped Silver Nanoparticles. Nanomaterials. 2020; 10(9):1861. https://doi.org/10.3390/nano10091861
Chicago/Turabian StyleElgamouz, Abdelaziz, Hamid Idriss, Chahlaa Nassab, Alaa Bihi, Khalid Bajou, Kamrul Hasan, Mohammad Abu Haija, and Shashikant P. Patole. 2020. "Green Synthesis, Characterization, Antimicrobial, Anti-Cancer, and Optimization of Colorimetric Sensing of Hydrogen Peroxide of Algae Extract Capped Silver Nanoparticles" Nanomaterials 10, no. 9: 1861. https://doi.org/10.3390/nano10091861
APA StyleElgamouz, A., Idriss, H., Nassab, C., Bihi, A., Bajou, K., Hasan, K., Abu Haija, M., & Patole, S. P. (2020). Green Synthesis, Characterization, Antimicrobial, Anti-Cancer, and Optimization of Colorimetric Sensing of Hydrogen Peroxide of Algae Extract Capped Silver Nanoparticles. Nanomaterials, 10(9), 1861. https://doi.org/10.3390/nano10091861

